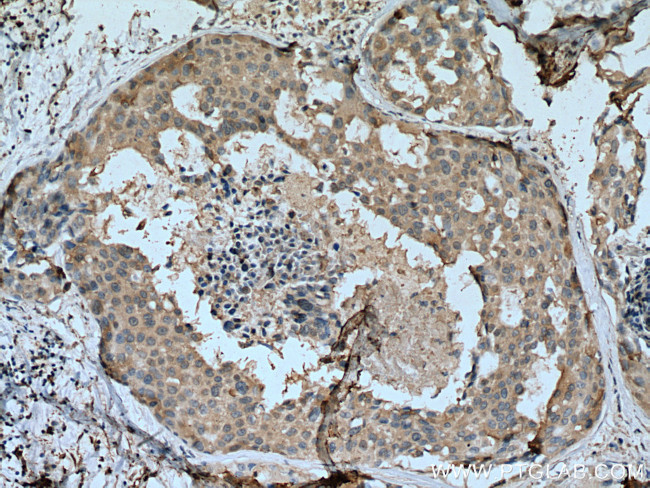
SCLY Antibody in Immunohistochemistry (Paraffin) (IHC (P))

Search
Proteintech
SCLY Monoclonal Antibody (3A2G7)
{{$productOrderCtrl.translations['antibody.pdp.commerceCard.promotion.promotions']}}
{{$productOrderCtrl.translations['antibody.pdp.commerceCard.promotion.viewpromo']}}
{{$productOrderCtrl.translations['antibody.pdp.commerceCard.promotion.promocode']}}: {{promo.promoCode}} {{promo.promoTitle}} {{promo.promoDescription}}. {{$productOrderCtrl.translations['antibody.pdp.commerceCard.promotion.learnmore']}}
产品信息
67606-1-IG
种属反应
宿主/亚型
分类
类型
克隆号
抗原
偶联物
形式
浓度
纯化类型
保存液
内含物
保存条件
运输条件
产品详细信息
Aliquoting is unnecessary for -20°C storage.
靶标信息
The SCLY gene encodes selenocysteine lyase, an enzyme involved in selenium metabolism, which plays a critical role in the recycling of selenocysteine from selenoproteins. SCLY catalyzes the conversion of selenocysteine into alanine, releasing selenium for reuse in the biosynthesis of new selenoproteins. It is chiefly active in the liver and kidneys, contributing to maintaining selenium homeostasis, which is vital for numerous biological functions due to selenium's role in antioxidant defense and thyroid hormone metabolism. Alterations in SCLY function or expression can affect selenium levels in the body and are associated with disorders related to oxidative stress and metabolic imbalances. Given the importance of selenium in cellular protection and immune function, SCLY is also of interest in studies focusing on dietary supplementation and disease prevention strategies, particularly in conditions like cancer and cardiovascular diseases where oxidative damage is prevalent.
仅用于科研。不用于诊断过程。未经明确授权不得转售。
篇参考文献 (0)
生物信息学
蛋白别名: hSCL; Selenocysteine lyase
基因别名: hSCL; SCL; SCLY
UniProt ID: (Human) Q96I15, (Rat) Q68FT9
Entrez Gene ID: (Human) 51540, (Rat) 363285